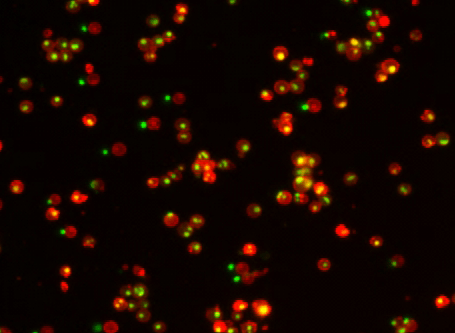

Annexin V
Annexin V (annexin A5) is one of the cellular proteins in the annexin family, a group of proteins that bind to anionic phospholipids in a Ca2+ dependent process. Its function within the cell is unclear, although mechanisms indicate it is mainly involved in coagulation processes. In cell health analysis, annexin V is regularly used to identify apoptotic cells by binding explicitly to phosphatidylserine (PS). PS is a protein that resides on the inner leaflet of the plasma membrane until the apoptotic process begins, whereby it translocates to the outer leaflet. Conjugates of annexin V are usually labeled with fluorophores, phycobiliproteins, or hapten molecules (e.g., biotin) to facilitate detection and quantification. (2)
Fig. 1

Annexin V conjugates identify cells in the early stages of apoptosis by binding to PS residues that have translocated to the outer leaflet of the plasma membrane.
During early-stage apoptosis, the plasma membrane undergoes structural changes resulting in the translocation of phosphatidylserine (PS) from the inner cytoplasmic side of the plasma membrane to the outer leaflet of the cell. Once PS has been translocated to the extracellular surface, annexin V conjugates will bind explicitly to the exposed PS residues and stain apoptotic cells. Since annexin V conjugates are impermeant and cannot cross the plasma membrane, live healthy cells will not be stained. (2), (7)
Fig. 2

Annexin V-FITC (Catalog Number 20030) was used to identify levels of apoptosis in HeLa cells. HeLa cells were treated with low concentrations of EtOH to induce apoptosis and then stained with annexin V-FITC. The green label on the plasma membrane (Annexin V-FITC) indicates cells undergoing apoptosis.
Yes, annexin V can stain necrotic cells. Necrosis is the term for unnatural cell death and can be triggered by various events, including lack of blood and oxygen to tissues or acute trauma to a cellular area. One key characteristic of necrotic cells is the rupturing of the plasma membrane. This event allows annexin V to access the entire plasma membrane, including the inner leaflet where PS residues reside, resulting in false positives. Therefore, it is recommended to use a cell impermeant stain, such as propidium iodide (PI) or 7-AAD, in combination with annexin V conjugates to negate false positives and differentiate apoptotic cells from dead ones. (1), (7)
Fig. 3

Fluorescence determination of live, apoptotic, and necrotic Jurkat cells. Jurkat cells were treated with 1 µM staurosporine for 3 hours to induce apoptosis, and then stained with three fluorescent probes to identify health status. Live cells are stained blue using viability dye CytoCalcein™ Violet 450 (Catalog Number 22012), apoptotic cells are stained green using Annexin V-FITC (Catalog Number 20030), and necrotic cells are stained red using 7-AAD (Catalog Number 17501). Note: Due to the rupturing of their membranes, necrotic cells can also be stained by annexin V-FITC as indicated by cells with red fluorescent nuclei and green fluorescent plasma membranes.
An annexin V/PI assay is used to differentiate cells in the early stages of apoptosis via annexin V labeling from necrotic/dead cells via propidium iodide (PI) labeling. In the early stages of apoptosis, the cell membrane begins to lose asymmetry, which leads to the translocation of phosphatidylserine (PS) to the membrane's outer surface, where annexin V conjugates can detect it. However, in cases where the cellular membrane has ruptured, such as necrosis, annexin V conjugates can access and bind to PS residues in the inner leaflet, resulting in false positives. Therefore, using a membrane-impermeant nuclear stain, such as PI, with annexin V conjugates is recommended. This allows the user to distinguish between cells in early apoptosis (annexin V stained), late apoptosis (annexin V and PI stained), and necrotic cells (PI only). (5)
Fig. 4

Diagram of an annexin V and PI assay.
Yes, cells can be fixed post annexin V staining. To fixate cells, satisfy the following conditions:
- Use aldehyde-based fixation methods free of alcohol
- Use buffers containing CaCl2
- Avoid using detergents or surfactants
Never fix cells before annexin V staining. Fixing cells kills them, and annexin V staining can only be done on live cells or tissues. (4)
No, annexin V is not an antibody. Annexin V is a 36.8 kDa calcium-dependent cellular protein that binds selectively to the anionic phospholipid phosphatidylserine (PS) in a calcium-dependent manner. While its function within the cells is not entirely clear, it is believed to be involved in coagulation or clotting mechanisms of the body. In cell health analysis, annexin V staining is used to detect apoptotic cells.
Anti-annexin V antibodies are used to detect the presence of annexin V proteins in applications such as Western Blot, ICC, IHC, flow cytometry, or ELISA. They are typically conjugated to enzymes, fluorophores, phycobiliproteins, or hapten molecules to facilitate detection. (6)
An annexin V positive result indicates cells that are in the early stages of apoptosis. This term is usually used in the context of an annexin V/PI assay to differentiate cell populations based on their health status. Other terms include:
- Annexin V negative/PI negative: this indicates healthy cells
- Annexin V positive/PI positive: this indicates necrotic or late apoptotic cells(7)
Annexin V binding buffers facilitate the binding of annexin V to phosphatidylserine (PS) in a given sample. These binding buffers need to contain calcium at a high enough concentration such that annexin V binds to PS, but not so high that it starts binding to other phospholipids. Annexin V binding buffers can also be used to wash the sample free of excess annexin V and other residual chemicals to ensure accurate detection. Before staining, cells should be resuspended in annexin V binding buffer at a concentration of 1x106/mL. (2)
An annexin V binding buffer can be made using the following recipe:
- 10 mM HEPES (pH 7.4)
- 150 mM NaCl
- 2.5 mM CaCl2
- Prepared in PBS (pH 7.4)
By itself, annexin V is colorless and difficult to measure. To detect the binding of annexin V to phosphatidylserine, annexin V is usually conjugated to fluorescein isothiocyanate (FITC), a green fluorescent compound featuring an excitation peak of 491 nm and an emission peak of 516 nm. Labeling annexin V with FITC or any other green fluorescent dye, such as iFluor® 488 (Ex/Em = 491/516 nm), facilitates multiplex analysis with red and far-red fluorescent probes, with little compensation. One example is the popular red-fluorescent dead cell stain propidium iodide (PI) which has an emission maximum at 618 nm. Together Annexin V-FITC and PI can be used to differentiate between apoptotic populations from necrotic populations in complex samples. (2), (8)
Annexin V identifies cells undergoing apoptosis by binding to phosphatidylserine (PS) residues exposed on the extracellular side of their plasma membranes. In live healthy cells, PS residues reside within the inner leaflet of the plasma membrane, where they are inaccessible to annexin V binding. As cells initiate programmed cell death (apoptosis), their plasma membranes lose asymmetry. PS residues translocate from the inner to the outer leaflet of the membrane, where they become accessible to annexin V binding. Annexin V is typically conjugated with a fluorophore, such as FITC to facilitate the detection of apoptotic cells. (7)
An annexin V positive control is cells induced to undergo apoptosis using a known apoptosis induction method. When stained with an annexin V conjugate (e.g., Annexin V-FITC), these cells will produce a positive signal. For example, apoptosis can be induced by heating cells at 55 °C for 20 minutes or treating cells agents known to induce apoptosis, such as camptothecin or staurosporine. (7)
Fig. 6

Images of Jurkat cells in a Costar black wall/clear bottom 96-well plate stained with Annexin V-iFluor 594 conjugate. Left: Untreated control cells. right: Cells treated with 20 µM camptothecin for 5 hours.
Terminal deoxynucleotidyl transferase dUTP nick end labeling (TUNEL) is a staining method used to identify sites of DNA fragmentation within cells—a hallmark characteristic of late-stage apoptosis. It uses the enzyme terminal deoxynucleotidyl transferase (TdT) to attach modified dNTPs (e.g., dUTP) to the 3'-hydroxyl terminus of fragmented DNA strands. dNTPs are typically modified with fluorophores to facilitate quantification and/or visualization.
Annexin V staining identifies cells in the early stages of apoptosis by binding to extracellularly exposed PS residues due to loss of cell membrane asymmetry. Annexin V is typically labeled with fluorophores such as FITC to facilitate the detection of apoptotic cells. (3)
Fig. 7

TUNEL assay of formalin-fixed paraffin-embedded (FFPE) human lung adenocarcinoma sections with Cell Meter™ Fixed Cell and Tissue TUNEL Apoptosis Assay Kit Green Fluorescence (Catalog Number 22851). DNA strand breaks showed intense fluorescent staining in DNAse treated tissue section. Cell nucleus was stained with Nuclear Blue™ DCS1 (Catalog Number 17548).
- Crowley, L. C., Marfell, B. J., Scott, A. P., & Waterhouse, N. J. (2016). Quantitation of Apoptosis and Necrosis by Annexin V Binding, Propidium Iodide Uptake, and Flow Cytometry. Cold Spring Harbor protocols, 2016(11), 10.1101/pdb.prot087288. https://doi.org/10.1101/pdb.prot087288
- Logue, S., Elgendy, M. & Martin, S. Expression, purification and use of recombinant annexin V for the detection of apoptotic cells. Nat Protoc 4, 1383–1395 (2009). https://doi.org/10.1038/nprot.2009.143
- Loo D. T. (2002). TUNEL assay. An overview of techniques. Methods in molecular biology (Clifton, N.J.), 203, 21–30. https://doi.org/10.1385/1-59259-179-5:21
- Mariotti, S., Pardini, M., Teloni, R., Gagliardi, M. C., Fraziano, M., & Nisini, R. (2017). A method permissive to fixation and permeabilization for the multiparametric analysis of apoptotic and necrotic cell phenotype by flow cytometry. Cytometry. Part A : the journal of the International Society for Analytical Cytology, 91(11), 1115–1124. https://doi.org/10.1002/cyto.a.23268
- Rieger, A. M., Nelson, K. L., Konowalchuk, J. D., & Barreda, D. R. (2011). Modified annexin V/propidium iodide apoptosis assay for accurate assessment of cell death. Journal of visualized experiments : JoVE, (50), 2597. https://doi.org/10.3791/2597
- Shojaie, M., Sotoodah, A., Roozmeh, S. et al. Annexin V and anti-Annexin V antibodies: two interesting aspects in acute myocardial infarction. Thrombosis J 7, 13 (2009). https://doi.org/10.1186/1477-9560-7-13
- van Engeland, M., Nieland, L. J., Ramaekers, F. C., Schutte, B., & Reutelingsperger, C. P. (1998). Annexin V-affinity assay: a review on an apoptosis detection system based on phosphatidylserine exposure. Cytometry, 31(1), 1–9. 3.0.co;2-r" target="_blank" rel="noopener">https://doi.org/10.1002/(sici)1097-0320(19980101)31:13.0.co;2-r
- Zhang, G., Gurtu, V., Kain, S. R., & Yan, G. (1997). Early detection of apoptosis using a fluorescent conjugate of annexin V. BioTechniques, 23(3), 525–531. https://doi.org/10.2144/97233pf01
This document (02.0167.211115r1) was last updated on Thu Oct 23 2025. All trademarks and registered trademarks mentioned herein are the property of their respective owners.
Annexin V